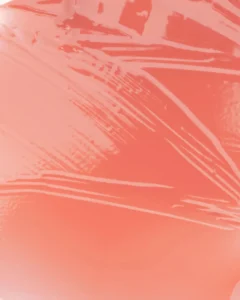

Muzigae Mansion Icy Glow 006 Better
Country of Origin:Â Â Â Â Â Â Â Â Â Â South Korea
Conscious:Â Â Â Â Â Â Â Â Â Â Â Â Â Â Â Â Â Cruelty Free
Concern:Â Â Â Â Â Â Â Â Â Â Â Â Â Â Â Â Â Â Â Dryness, Dullness, Uneven Tone
Benefits:Â Â Â Â Â Â Â Â Â Â Â Â Â Â Â Â Â Â Â Glossy Finish, Hydrating, Subtle Tint
Super Ingredients:Â Â Â Â Â Â Â Â Phytosqualane, Tocopherol, Hydrogenated Polyisobutene
Net Volume:Â Â Â Â Â Â Â Â Â Â Â Â Â Â Â 5 ml
Net Quantity:Â Â Â Â Â Â Â Â Â Â Â Â Â 1 N
Formulation:Â Â Â Â Â Â Â Â Â Â Â Â Â Oil-Gel Tint
Preference:Â Â Â Â Â Â Â Â Â Â Â Â Â Â Â Vegan, Cruelty Free, Lightweight
Skin Type:Â Â Â Â Â Â Â Â Â Â Â Â Â Â Â All Skin Types
Muzigae Mansion Icy Glow 006 Better
Description
Meet your lips’ effortless enhancer—the Muzigae Mansion Icy Glow 006 Better (5 ml).
This crystal-clear oil-gel tint delivers a sheer, radiant glow with a whisper of warm beige-nude—perfect for everyday elegance. Shade 006 Better gives a subtle, your-lips-but-better finish that enhances natural tone while adding glass-like luminosity.
Its ultra-lightweight formula glides seamlessly, coating lips in nourishing hydration without stickiness. Whether used alone for a clean glossy look or layered for extra impact, this tint flatters all skin tones and elevates any makeup routine with its barely-there, polished finish.
Key Features & Benefits:
-
Delivers a soft nude-beige glow with high shine
-
Gel-oil formula hydrates and smooths lips instantly
-
Comfortable non-sticky wear with a plumping effect
-
Subtle color payoff perfect for daily wear or glassy layering
-
Compact sculptural packaging adds a chic touch to your vanity
Key Ingredients:
-
Phytosqualane: Mimics skin’s natural oils for deep hydration and smoothness
-
Tocopherol (Vitamin E): Fights free radicals and prevents lip dryness
-
Hydrogenated Polyisobutene: Offers lasting shine and silky application
How to Use:
Swipe the tint evenly over lips using the applicator. Reapply to build up shine or pair it with a lip liner or lipstick for a multidimensional effect.
Reviews (0)
Reviews
There are no reviews yet.

-
(0 customer reviews)